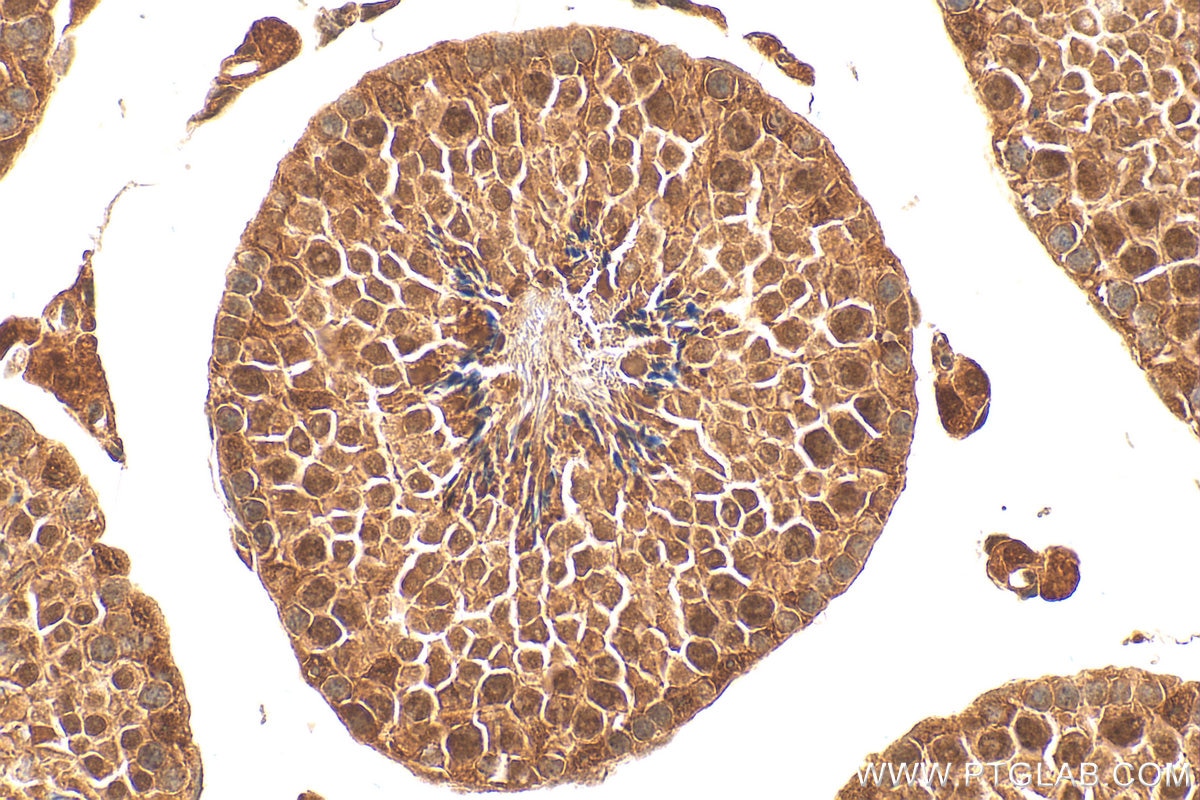
IHC staining of mouse testis using 28686-1-AP Immunohistochemistry (IHC) staining of mouse testis tissue using Ajuba Polyclonal antibody (28686-1-AP)

Tested Applications
| Positive WB detected in | HeLa cells, HepG2 cells |
| Positive IHC detected in | mouse skin tissue, human skin cancer tissue, human thyroid cancer tissue, mouse kidney tissue, mouse small intestine tissue, mouse testis tissue, rat skin tissue, rat small intestine tissue, rat testis tissue Note: suggested antigen retrieval with TE buffer pH 9.0; (*) Alternatively, antigen retrieval may be performed with citrate buffer pH 6.0 |
Recommended dilution
| Application | Dilution |
|---|---|
| Western Blot (WB) | WB : 1:1000-1:6000 |
| Immunohistochemistry (IHC) | IHC : 1:500-1:2000 |
| It is recommended that this reagent should be titrated in each testing system to obtain optimal results. | |
| Sample-dependent, Check data in validation data gallery. | |
Published Applications
| WB | See 1 publications below |
Product Information
28686-1-AP targets Ajuba in WB, IHC, ELISA applications and shows reactivity with human, mouse, rat samples.
| Tested Reactivity | human, mouse, rat |
| Cited Reactivity | human |
| Host / Isotype | Rabbit / IgG |
| Class | Polyclonal |
| Type | Antibody |
| Immunogen |
CatNo: Ag29725 Product name: Recombinant human JUB protein Source: e coli.-derived, PGEX-4T Tag: GST Domain: 1-173 aa of BC007580 Sequence: MERLGEKASRLLEKFGRRKGESSRSGSDGTPGPGKGRLSGLGGPRKSGPRGATGGPGDEPLEPAREQGSLDAERNQRGSFEAPRYEGSFPAGPPPTRALPLPQSLPPDFRLEPTAPALSPRSSFASSSASDASKPSSPRGSLLLDGAGAGGAGGSRPCSNRTSGISMGYDQRH Predict reactive species |
| Full Name | jub, ajuba homolog (Xenopus laevis) |
| Calculated Molecular Weight | 57 kDa |
| Observed Molecular Weight | 57 kDa |
| GenBank Accession Number | BC007580 |
| Gene Symbol | Ajuba |
| Gene ID (NCBI) | 84962 |
| RRID | AB_2881194 |
| Conjugate | Unconjugated |
| Form | Liquid |
| Purification Method | Antigen affinity purification |
| UNIPROT ID | Q96IF1 |
| Storage Buffer | PBS with 0.02% sodium azide and 50% glycerol, pH 7.3. |
| Storage Conditions | Store at -20°C. Stable for one year after shipment. Aliquoting is unnecessary for -20oC storage. 20ul sizes contain 0.1% BSA. |
Background Information
Ajuba belongs to the LIM domain proteins, which are involved in the assembly of the extracellular matrix and, along with associated proteins, regulate target genes that connect the extracellular matrix and the cytoskeleton. Ajuba consists of three LIM domains at the C-terminal and is located in the cytoplasm where it interacts with a variety of other proteins. Ajuba contributes to the formation or strengthening of cell-cell adhesion and regulates cell growth and differentiation decisions. Ajuba participates in the assembly of the extracellular matrix. Ajuba also plays an important role in some diseases.
Protocols
| Product Specific Protocols | |
|---|---|
| IHC protocol for Ajuba antibody 28686-1-AP | Download protocol |
| WB protocol for Ajuba antibody 28686-1-AP | Download protocol |
| Standard Protocols | |
|---|---|
| Click here to view our Standard Protocols |